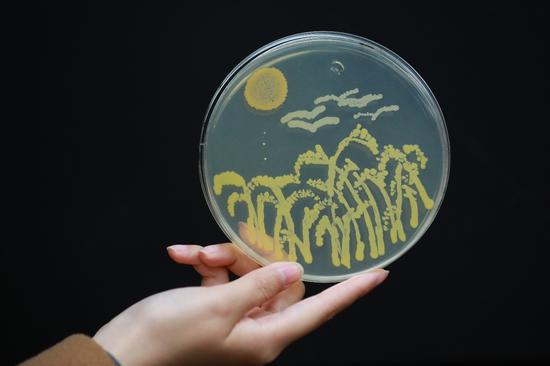
北京区复赛"生物环境"命题作品—细菌画《麦田》

用细菌作画

细菌也能画画作画过程令人震撼网友一般人画不出来
图片尺寸635x511
细菌也能画画作画过程令人震撼网友一般人画不出来
图片尺寸399x391
微生物主题画04.幼儿园小朋友也可以画的细菌主题画,天气暖, - 抖音
图片尺寸1440x1920
最后再添加一些细小的细菌,就特别丰富了
图片尺寸1440x1080
亲子水彩画课堂2022925细菌04来了
图片尺寸1080x1439
细菌也能画画?作画过程令人震撼,网友:一般人画不出来
图片尺寸864x647
art contest),也就是在培养皿里用细菌来作画,要正确引导细菌的生长
图片尺寸2000x1895
儿童画细菌大作战病毒新冠
图片尺寸1080x914
细菌微生物也可以作画这个艺术家做到了
图片尺寸1080x1351
华农学生用细菌作画获大奖
图片尺寸640x426
厉害!大连师生用细菌作画引央视关注
图片尺寸800x800
细菌画
图片尺寸3150x2186
因为它要求参赛者要以培养皿里的琼脂为画布,用细菌在上面作画
图片尺寸501x360
因为它要求参赛者要以培养皿里的琼脂为画布,用细菌在上面作画
图片尺寸501x501
科学家的另类艺术:细菌作画(多图)
图片尺寸688x413
沐恩幼儿园 "停课不停学"——科学小实验《消失的细菌》
图片尺寸1080x810
北京区复赛"生物环境"命题作品—细菌画《麦田》
图片尺寸550x366
细菌简笔画细菌简笔画图片
图片尺寸500x763
细菌大战
图片尺寸3200x2175
儿童创意画小手上的细菌王国45岁
图片尺寸1080x1045